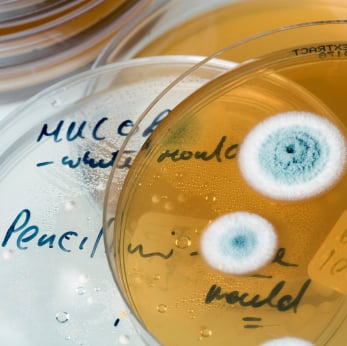

Lo scorso giugno ha destato non poca preoccupazione l'infezione causata dal microrganismo Escherichia coli. Nella sola Germania, epicentro del focolaio, si sono registrati più di 2500 casi e 45 decessi. Un'epidemia non prevedibile che ha lasciato disorientati anche gli addetti ai lavori. Spenti i riflettori per qualche mese, l'Escherichia coli torna alla ribalta grazie ad uno studio pubblicato dalla rivista Science. Secondo gli scienziati della Carnegie Mellon University di Pittsburgh (Stati Uniti), la tossina prodotta dal microrganismo potrebbe essere facilmente combattuta con un elemento chimico abbondante e a basso costo: il manganese.
IL MICRORGANISMO- L’Escherichia coli è un microrganismo presente comunemente nella flora intestinale degli uomini e, più in generale, dei mammiferi. Oltre ad essere innocuo possiede la capacità di modulare in maniera positiva la presenza di ulteriori batteri. Ciò garantisce all'organismo ospitante, cioè l'uomo, di mantenere integra la corretta funzionalità intestinale. Purtroppo però esistono diversi ceppi di Escherichia coli e alcuni di essi sono enteropatogeni, ovvero provocano infezioni, diarrea e in alcuni casi producono tossine pericolose che portano a morte cellulare. Una di esse prende il nome di Shiga, scoperta inizialmente essere prodotta nei microrganismi del genere Shigella. In particolare questa tossina è capace di bloccare la sintesi proteica, processo fondamentale per la sopravvivenza della cellula.
COME AGISCE?- Da tempo gli scienziati sono al lavoro per decifrare il complesso meccanismo che la tossina utilizza per colonizzare la cellula e provocarne la morte. Diversi studi hanno dimostrato che una proteina presente nelle cellule umane, GPP130, gioca un ruolo chiave nell'invasione. GPP130 infatti funge da vera e propria navetta in grado di trasportare la tossina in quei punti della cellula dove può fare danni. Al contrario, in assenza di essa, la tossina finisce per essere “demolita” dalla cellula.
LA RICERCA- Dunque bloccare l'attività di GPP130 potrebbe essere una delle strategie per evitare la morte delle cellule. Ed è proprio questa la direzione in cui si sono spinti gli scienziati statunitensi. Nello studio, svoltosi in modello animale, gli esperti hanno scoperto che a dosi non tossiche il manganese è capace di inattivare GPP130 rendendo quindi innocua la tossina shiga. Un risultato straordinario che potrebbe presto portare anche a dei risultati in campo terapeutico. La somministrazione di antibiotici infatti può paradossalmente essere fatale perchè i batteri muoiono rilasciando alte dosi di shiga. L'idea dei ricercatori è quindi quella di somministrare, insieme all'antibiotico, anche il manganese così da neutralizzare contemporaneamente sia il batterio sia la tossina prodotta.
LAVARSI LE MANI- La prevenzione rimane comunque l'arma più efficace per contrastare le infezioni da microrganismi. Ci sono poche e semplici norme igieniche di base che se rispettate in casa e in comunità possono assicurare una discreta protezione. In assoluto lavare spesso e accuratamente le mani con sapone, strofinandole bene (i microrganismi spariscono attraverso l’azione meccanica) è la migliore strategia. A differenza di quanto si crede invece conta meno la temperatura dell'acqua. Un microrganismo come l'Escherichia coli può infatti crescere a temperature vicine ai 45 gradi. Via libera dunque ai prodotti igienizzanti per le mani.